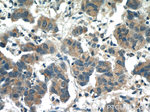
PIWIL1 Antibody in Immunohistochemistry (Paraffin) (IHC (P))
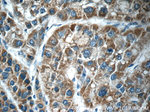
PIWIL1 Antibody in Immunohistochemistry (Paraffin) (IHC (P))
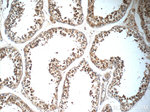
PIWIL1 Antibody in Immunohistochemistry (Paraffin) (IHC (P))

Search
Proteintech
PIWIL1 Polyclonal Antibody
{{$productOrderCtrl.translations['antibody.pdp.commerceCard.promotion.promotions']}}
{{$productOrderCtrl.translations['antibody.pdp.commerceCard.promotion.viewpromo']}}
{{$productOrderCtrl.translations['antibody.pdp.commerceCard.promotion.promocode']}}: {{promo.promoCode}} {{promo.promoTitle}} {{promo.promoDescription}}. {{$productOrderCtrl.translations['antibody.pdp.commerceCard.promotion.learnmore']}}
产品信息
15659-1-AP
种属反应
已发表种属
宿主/亚型
分类
类型
抗原
偶联物
形式
浓度
规格
纯化类型
保存液
内含物
保存条件
运输条件
产品详细信息
Immunogen sequence: MTGRARARA RGRARGQETA QLVGSTASQQ PGYIQPRPQP PPAEGELFGR GRQRGTAGGT AKSQGLQISA GFQELSLAER GGRRRDFHDL GVNTRQNLDH VKESKTGSSG IIVRLSTNHF RLTSRPQWAL YQYHIDYNPL MEARRLRSAL LFQHEDLIGK CHAFDGTILF LPKRLQQKVT EVFSKTRNGE DVRITITLTN ELPPTSPTCL QFYNIIFRRL LKIMNLQQIG RNYYNPNDPI DIPSHRLVIW PGFTTSILQY ENSIMLCTDV SHKVLRSETV LDFMFNFYHQ TEEHKFQEQV SKELIGLVVL TKYNNKTYRV DDIDWDQNPK STFKKADGSE VSFLEYYRKQ Y (1-350 aa encoded by BC028581)
靶标信息
Hiwi is a member of the Piwi /Argonaute protein family. Hiwi is specifically expressed in germline cells such as spermatocytes and round spermatids during spermatogenesis. Hiwi is also expressed in CD34+ hematopoietic progenitors, but not in CD34- hematopoietic cells, suggesting a role for this gene in the maintenance of hematopoietic stem cells.
仅用于科研。不用于诊断过程。未经明确授权不得转售。
生物信息学
蛋白别名: CT80; HILI; member of the PIWI family; mili; Miwi like; Miwi likw; piwi homolog; piwi like homolog 1; piwi-like homolog 1; Piwi-like protein 1; piwi-like protein 2; PIWIL1L; piwil2-like protein; unnamed protein product
基因别名: CT80.1; HIWI; MIWI; PIWI; PIWIL1
UniProt ID: (Human) Q96J94, (Mouse) Q9JMB7
Entrez Gene ID: (Human) 9271, (Mouse) 57749